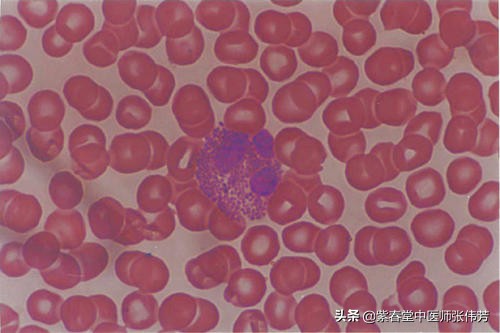
过敏性紫癜红点多长时间可以消退,过敏性紫癜红点消退后还需要忌口

过敏性紫癜是人体免疫激化状态下导致的血管变态反应性出血性疾病,是免疫应急反应引起的血管通透性以及脆性增加导致的出血,容易影响到胃肠道,关节,肾脏严重就是肾病综合征,肾脏衰竭,有生命的危险。
本病轻者常可自愈,但易复发。紫癜在2周、4周及大于4周消退者各占1/3,病程长者可达数年之久。

那么过敏性紫癜红点没有是痊愈吗?
过敏性紫癜治愈的标准:
1.首先是症状消失,紫癜不再反复。
2.各种化验指标正常,血常规,尿常规、肝功能、肾功能都无异常。
3.最主要是感冒发烧也不出紫癜。
4.活动与正常人一样,活动量大了病情也不反复。
5.也不再忌口了,海鲜、鸡蛋、羊肉牛肉都可以吃了。
满足以上五点,过敏性紫癜才算完全好了。

激素在过敏性紫癜治疗中如何选择应用,每个医生都会有不同的认识,也并没有谁对谁错之分。但是,对于患者来说,大部分人都拒绝激素。
我们所说的激素的副作用主要指的是肾上腺糖皮质激素。因为有某些原发病,我们需要长期应用糖皮质激素,那么长期应用这些糖皮质激素以后,会产生一系列的副作用。
长期应用糖皮质激素会加重骨质疏松,而且还会造成胃溃疡、消化性溃疡,也会造成高血压难以控制,还会诱导糖尿病的发生。继发性糖尿病是因为长期激素造成的。这些激素的副作用一般在停用激素两个月左右会消失,有的副作用可能会更长一些时间消失。